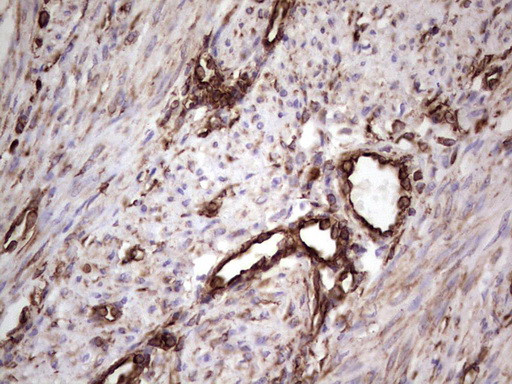
PRPH Antibody in Immunohistochemistry (Paraffin) (IHC (P))

Search
OriGene
PRPH Monoclonal Antibody (OTI1E10), TrueMAB™
{{$productOrderCtrl.translations['antibody.pdp.commerceCard.promotion.promotions']}}
{{$productOrderCtrl.translations['antibody.pdp.commerceCard.promotion.viewpromo']}}
{{$productOrderCtrl.translations['antibody.pdp.commerceCard.promotion.promocode']}}: {{promo.promoCode}} {{promo.promoTitle}} {{promo.promoDescription}}. {{$productOrderCtrl.translations['antibody.pdp.commerceCard.promotion.learnmore']}}
产品信息
TA806183
种属反应
宿主/亚型
分类
类型
克隆号
抗原
偶联物
形式
浓度
规格
纯化类型
保存液
内含物
保存条件
运输条件
靶标信息
Peripherin is a 57kD type III intermediate filament that is a specific marker for peripheral neurons, including enteric ganglion cells. Peripherin is expressed in the developing peripheral nervous system and is highly enriched in neuronal derivatives of the neural crest. Peripherin offers an advantage over other neural markers, such as S100 and NSE in that it does not stain chrmaffin cell types.
仅用于科研。不用于诊断过程。未经明确授权不得转售。
篇参考文献 (0)
生物信息学
蛋白别名: Neurofilament 4; neurofilament 4 (57kD); Peripherin; unnamed protein product
基因别名: NEF4; PRPH; PRPH1
UniProt ID: (Human) P41219
Entrez Gene ID: (Human) 5630